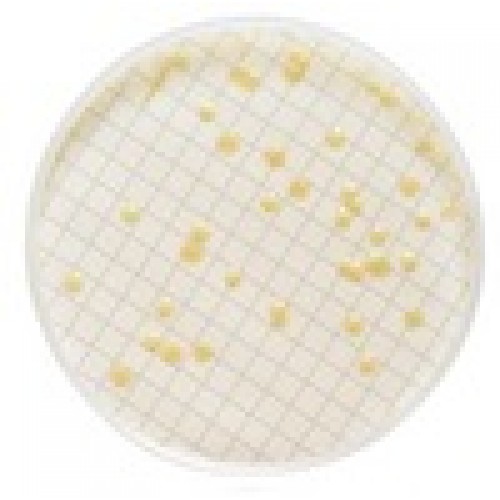

MILLIFLEX MEIO TRYPTIC SOY AGAR CONTAGEM TOTAL HETEROTROFICOS CONF. USP/EP VALIDADE MINIMA: 3 MESES (CX) MILLIPORE
Modelo: MXSMCTS48
-
R$3.880,87
ou até 3x de R$1.293,62 sem juros
Economize 5% no PIX: R$3.686,83
ou 3.5% no boleto: R$3.745,04